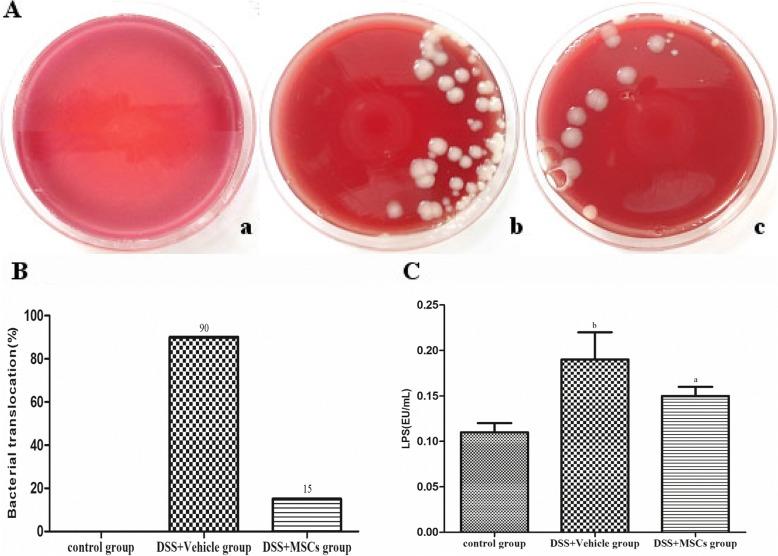
https://cdn.ncbi.nlm.nih.gov/pmc/blobs/ac88/6090774/9a657a516c9e/12876_2018_850_Fig4_HTML.jpg

间充质干细胞移植通过抑制小鼠体内Toll样受体4的活性来改善慢性结肠炎相关并发症。
Mesenchymal stem cell transplantation improves chronic colitis-associated complications through inhibiting the activity of toll-like receptor-4 in mice.
作者信息
Niu Guo Chao, Liu Lei, Zheng Libo, Zhang Hong, Shih David Q, Zhang Xiaolan
机构信息
Department of Gastroenterology, The Second Hospital of Hebei Medical University, No.80 Huanghe Avenue, Shijiazhuang, Hebei, 050035, People's Republic of China.
Hebei Key Laboratory of Gastroenterology, Shijiazhuang, People's Republic of China.
出版信息
BMC Gastroenterol. 2018 Aug 13;18(1):127. doi: 10.1186/s12876-018-0850-7.
BACKGROUND
A variety of extra-intestinal manifestations (EIMs), including hepatobiliary complications, are associated with inflammatory bowel disease (IBD). Mesenchymal stem cells (MSCs) have been shown to play a potential role in the therapy of IBD. This study was designed to investigate the effect and mechanism of MSCs on chronic colitis-associated hepatobiliary complications using mouse chronic colitis models induced by dextran sulfate sodium (DSS).
METHODS
DSS-induced mouse chronic colitis models were established and treated with MSCs. Severity of colitis was evaluated by disease activity index (DAI), body weight (BW), colon length and histopathology. Serum lipopolysaccharide (LPS) levels were detected by limulus amebocyte lysate test (LAL-test). Histology and liver function of the mice were checked correspondingly. Serum LPS levels and bacterial translocation of mesenteric lymph nodes (MLN) were detected. Pro-inflammatory cytokines including tumor necrosis factor-α (TNF-α), interferon-γ (IFN-γ), interleukin-1β (IL-1β), interleukin-17A (IL-17A), Toll receptor 4 (TLR4), TNF receptor-associated factor 6 (TRAF6) and nuclear factor kappa B (NF-κB) were detected by immunohistochemical staining, western blot analysis and real-time PCR, respectively.
RESULTS
The DSS-induced chronic colitis model was characterized by reduced BW, high DAI, worsened histologic inflammation, and high levels of LPS and E. coli. Liver histopathological lesions, impaired liver function, enhanced proteins and mRNA levels of TNF-α, IFN-γ, IL-1β, IL-17A, TLR4, TRAF6 and NF-κB were observed after DSS administration. MSCs transplantation markedly ameliorated the pathology of colon and liver by reduction of LPS levels and proteins and mRNA expressions of TNF-α, IFN-γ, IL-1β, IL-17A, TLR4, TRAF6 and NF-κB.
CONCLUSIONS
MSCs can improve chronic colitis-associated hepatobiliary complications, probably by inhibition of enterogenous endotoxemia and hepatic inflammation through LPS/TLR4 pathway. MSCs may represent a novel therapeutic approach for chronic colitis-associated hepatobiliary complications.
背景
包括肝胆并发症在内的多种肠外表现(EIMs)与炎症性肠病(IBD)相关。间充质干细胞(MSCs)已被证明在IBD治疗中发挥潜在作用。本研究旨在利用葡聚糖硫酸钠(DSS)诱导的小鼠慢性结肠炎模型,研究MSCs对慢性结肠炎相关肝胆并发症的影响及机制。
方法
建立DSS诱导的小鼠慢性结肠炎模型并用MSCs进行治疗。通过疾病活动指数(DAI)、体重(BW)、结肠长度和组织病理学评估结肠炎的严重程度。通过鲎试剂检测法(LAL检测)检测血清脂多糖(LPS)水平。相应地检查小鼠的组织学和肝功能。检测血清LPS水平和肠系膜淋巴结(MLN)的细菌移位。分别通过免疫组织化学染色、蛋白质印迹分析和实时PCR检测促炎细胞因子,包括肿瘤坏死因子-α(TNF-α)、干扰素-γ(IFN-γ)、白细胞介素-1β(IL-1β)、白细胞介素-17A(IL-17A)、Toll受体4(TLR4)、肿瘤坏死因子受体相关因子6(TRAF6)和核因子κB(NF-κB)。
结果
DSS诱导的慢性结肠炎模型的特征为体重减轻、DAI升高、组织学炎症加重以及LPS和大肠杆菌水平升高。给予DSS后观察到肝脏组织病理学损伤、肝功能受损、TNF-α、IFN-γ、IL-1β、IL-17A、TLR4、TRAF6和NF-κB的蛋白质和mRNA水平升高。MSCs移植通过降低LPS水平以及TNF-α、IFN-γ、IL-1β、IL-17A、TLR4、TRAF6和NF-κB的蛋白质和mRNA表达,显著改善了结肠和肝脏的病理状况。
结论
MSCs可能通过LPS/TLR4途径抑制肠源性内毒素血症和肝脏炎症,从而改善慢性结肠炎相关的肝胆并发症。MSCs可能代表了一种治疗慢性结肠炎相关肝胆并发症的新方法。